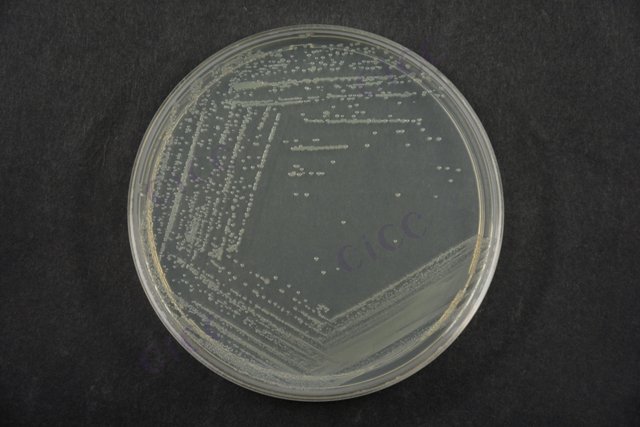
肠道集聚性大肠埃希氏菌 Escherichia coli EAEC CICC 24186 Escherichia coli EAEC

肠道集聚性大肠埃希氏菌 Escherichia coli EAEC CICC 24186 Escherichia coli EAEC
-
肠道集聚性大肠埃希氏菌EAEC Escherichia coli EAEC CICC 25044 Escherichia coli EAEC
CICC 25044 | 见证书
-
肠道出血性大肠埃希氏菌 Escherichia coli EHEC CICC 24187 Escherichia coli EHEC
CICC 24187 | 见证书
-
肠道致病性大肠埃希氏菌 Escherichia coli EPEC CICC 24189 Escherichia coli EPEC
CICC 24189 | 见证书
-
肠道侵袭性大肠埃希氏菌 Escherichia coli EIEC CICC 24188 Escherichia coli EIEC
CICC 24188 | 见证书
-
肠道致病性大肠埃希氏菌EPEC Escherichia coli EPEC CICC 25042 Escherichia coli EPEC
CICC 25042 | 见证书
-
肠道出血性大肠埃希氏菌EHEC Escherichia coli EHEC CICC 25043 Escherichia coli EHEC
CICC 25043 | 见证书
-
肠道侵袭性大肠埃希氏菌 Escherichia coli EIEC CICC 10662 Escherichia coli EIEC
CICC 10662 | 见证书

说明书下载: 菌种说明书 打管说明书
您正在浏览的产品:肠道集聚性大肠埃希氏菌 Escherichia coli EAEC CICC 24186
手机版:肠道集聚性大肠埃希氏菌 Escherichia coli EAEC CICC 24186
本公司销售的所有产品仅供实验科研使用,不用于人体及临床诊断。
2. 选择性增菌:转种肠道菌增菌肉汤二次培养
3. 分离培养:接种MAC和CT-SMAC平板
4. 生化鉴定:IMViC试验(吲哚、MR、VP、柠檬酸盐)
5. PCR检测:特异性基因aggR(EAEC特征基因)[4][10]
2. 对贝类等特殊样品需增加60℃ 15秒热处理步骤
3. 实验废弃物需121℃高压灭菌30分钟处理[4][10]
以上信息仅供参考,请以相应标准的原文为准!